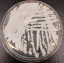

EU-SEARCH NOVICE | Tukaj so empirični dokazi, da se je nad vsemi nami cepljenimi izvršil zločin ...
 Tukaj so empirični dokazi, da se je nad vsemi nami cepljenimi izvršil zločin
Tukaj so empirični dokazi, da se je nad vsemi nami cepljenimi izvršil zločin
(04.12.2023) | newsexchange ...
Da se ve kaj so nam storili. Tukaj bomo zdaj objavili s presledki vsakega govornika -strokovnjaka ki je včeraj v HR SABORU povedal kar bi morali vedeti vsi. ... | Podobno 
EU-SEARCH NOVICE | Italijanski minister za zdravje je postal prvi pomemben akter, ki se je soočil z več obtožbami umorov zaradi povzročene smrti s cepivom COVID ...
 Italijanski minister za zdravje je postal prvi pomemben akter, ki se je soočil z več obtožbami umorov zaradi povzročene smrti s cepivom COVID
Italijanski minister za zdravje je postal prvi pomemben akter, ki se je soočil z več obtožbami umorov zaradi povzročene smrti s cepivom COVID
(13.12.2023) | newsexchange ...
Italijanski minister za zdravje Roberto Speranza je postal prvi svetovni voditelj, ki se sooča z več obtožbami umorov zaradi milijonov smrti, ki so jih povzročila cepiva mRNA."Nekdanji ... | Podobno 
EU-SEARCH NOVICE | V zvezni državi Washington so potrdili prvi izbruh smrtonosne glivične okužbe ...
 V zvezni državi Washington so potrdili prvi izbruh smrtonosne glivične okužbe
V zvezni državi Washington so potrdili prvi izbruh smrtonosne glivične okužbe
(02.02.2024) | newsexchange ...
Oblasti v zvezni državi Washington so potrdile izbruh smrtonosne glivične okužbe, ki je v zadnjih letih v porastu po ZDA.Uradniki v okrožju King v Washingtonu so v torek izjavili, ... | Podobno 
EU-SEARCH NOVICE | Novi dokazi kažejo, da je bil COVID-19 gensko spremenjeno biološko orožje, ki so ga ustvarili globalisti ...
 Novi dokazi kažejo, da je bil COVID-19 gensko spremenjeno biološko orožje, ki so ga ustvarili globalisti
Novi dokazi kažejo, da je bil COVID-19 gensko spremenjeno biološko orožje, ki so ga ustvarili globalisti
(06.02.2024) | newsexchange ...
Po novih dokazih je bil COVID-19 ustvarjen v laboratoriju kot biološko orožje za depopulacijo, ki se uporablja proti človeštvu.Emily Kopp iz neprofitne raziskovalne skupine za javno ... | Podobno 
EU-SEARCH NOVICE | Novi dokazi dokazujejo, da je Fauci lagal in trdil, da komaj pozna znanstvenika za koronavirus Ralpha Barica ...
 Novi dokazi dokazujejo, da je Fauci lagal in trdil, da komaj pozna znanstvenika za koronavirus Ralpha Barica
Novi dokazi dokazujejo, da je Fauci lagal in trdil, da komaj pozna znanstvenika za koronavirus Ralpha Barica
(21.04.2024) | newsexchange ...
FauciNedavno odkriti videoposnetek – oglejte si ga spodaj – dokazuje, da je zloglasni Tony Fauci lagal pod prisego, ko je zanikal, da bi prej poznal Ralpha ... | Podobno 
EU-SEARCH NOVICE | Kako smo dobili "prvi polčas" tekme za prevlado nad našim zdravjem ...
 Kako smo dobili "prvi polčas" tekme za prevlado nad našim zdravjem
Kako smo dobili "prvi polčas" tekme za prevlado nad našim zdravjem
(02.06.2024) | newsexchange ...
Odpor ni zaman!Podobno 
EU-SEARCH NOVICE | V zadevi Assange manjkajo ključni dokazi ...
 V zadevi Assange manjkajo ključni dokazi
V zadevi Assange manjkajo ključni dokazi
(21.06.2024) | newsexchange ...
Julian AssangeŠpanski primer proti človeku, čigar podjetje je domnevno vohunilo za Julianom Assangeom za ameriško vlado, je naletel na oviro zaradi ključnih ... | Podobno 
EU-SEARCH NOVICE | Začel je veljati prvi na svetu, celovit zakon EU o umetni inteligenci ...
 Začel je veljati prvi na svetu, celovit zakon EU o umetni inteligenci
Začel je veljati prvi na svetu, celovit zakon EU o umetni inteligenci
(01.08.2024) | newsexchange ...
Danes je začel veljati zakon Evropske unije o umetni inteligenci, za katerega v Bruslju obljubljajo, da bo spodbujal inovacije in hkrati ščitil pravice državljanov.V začetku tega ... | Podobno 
EU-SEARCH NOVICE | Dve leti po napadu na Severni tok je bil pridobljen prvi nalog za aretacijo ...
 Dve leti po napadu na Severni tok je bil pridobljen prvi nalog za aretacijo
Dve leti po napadu na Severni tok je bil pridobljen prvi nalog za aretacijo
(14.08.2024) | newsexchange ...
Na videz nezainteresiran odgovor zvezne vlade na vprašanje AfD o razstrelitvi plinovoda Severni tok je pravkar povzročil nerazumevanje med nemškim prebivalstvom. Zdaj je po poročanju medijev pridobljen ... | Podobno 
EU-SEARCH NOVICE | Izpostavljenost in neizpodbitni dokazi! Fauci, Gates in Moderna, neposredno odgovorni za pandemijo COVID-19 ...
Izpostavljenost in neizpodbitni dokazi! Fauci, Gates in Moderna, neposredno odgovorni za pandemijo COVID-19
Izpostavljenost in neizpodbitni dokazi! Fauci, Gates in Moderna, neposredno odgovorni za pandemijo COVID-19
(09.09.2024) | newsexchange ...
Nobenega dvoma ni več, da je bila celotna prevara COVID načrtovana precej vnaprej. Vendar pobudniki dogajanja v zadnjih letih niso niti poskušali zabrisati sledi, ki nezmotljivo kažejo, da je bilo ... | Podobno 
|